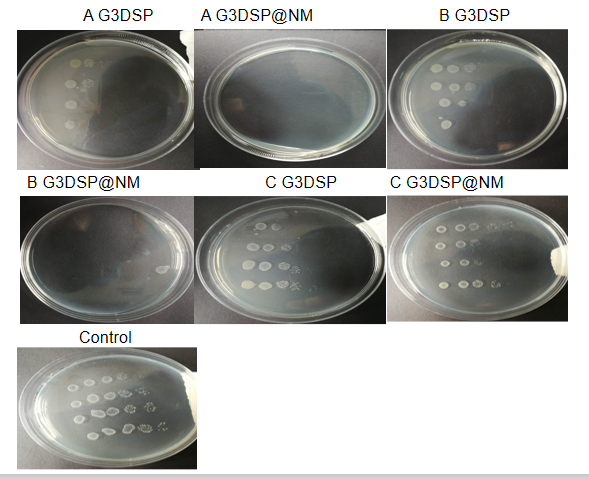
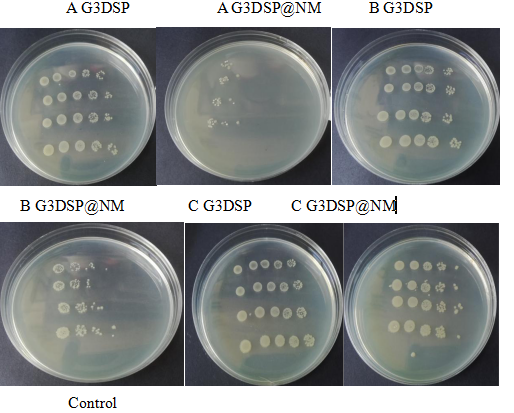

基于树状多肽纳米凝胶的新型抗菌剂的合成与表征毕业论文
2020-04-22 19:36:06
摘 要
本篇文首先对抗菌药物,抗菌材料性能评价方法,树状多肽大分子的研究现状,优良性能和硫酸新霉素的抗菌机制及抗菌情况进行了细致的阐述。本课题使用第三代赖氨酸与DSP交联剂在DMF溶液中制备的G3DSP纳米凝胶与G3DSP@NM纳米凝胶,并对其表征,发现粒径分布较为稳定,但G3DSP@NM纳米凝胶与G3DSP纳米凝胶相比的粒径变大,G3DSP纳米凝胶最大电位为 37.5 mV,然而G3DSP@NM纳米凝胶最大电位为 59.2 mV,电位更大。由以上得出结论,硫酸新霉素已负载入树状多肽大分子空腔中。
对本文过对于大肠杆菌和金葡萄球菌进行的抗菌性能测试表明G3DSP@NM纳米凝胶比G3DSP纳米凝胶对抗菌效果更加明显,并且得到的G3DSP@NM纳米凝胶抗菌剂抗菌效果明显。且使用场发射电字扫描显微镜观察细菌死亡时的形貌特征,更直观察出的细菌死亡后的具体形态。并使用共聚焦电子显微镜通过荧光染色,观察细菌实质死亡情况。
关键词:抗菌 纳米凝胶 树状多肽大分子 硫酸新霉素
Synthesis and characterization of novel antibacterial agents based on dendritic peptide nanogels
Abstract
This experimental design first elaborated on the antibacterial drugs, the evaluation methods of antibacterial materials, the research status of dendrimer macromolecules, the excellent performance and the antibacterial mechanism and antibacterial condition of neomycin sulfate. In this paper, G3DSP nanogel and G3DSP@NM nanogel prepared by using third-generation lysine and DSP cross-linking agent in DMF solution were characterized and found to be stable in particle size distribution, but G3DSP@NM nano-condensation. The particle size of the gel is larger than that of the G3DSP nanogel. The maximum potential of the G3DSP nanogel is 37.5 mV. However, the maximum potential of the G3DSP@NM nanogel is 59.2 mV, and the potential is larger. From the above it is concluded that neomycin sulfate has been loaded into the macromolecular cavity of the dendrimer.
The antibacterial performance test of E. coli and Staphylococcus aureus by this experiment showed that the antibacterial effect of G3DSP@NM nanogel was more obvious than that of G3DSP nanogel, and the antibacterial effect of G3DSP@NM nanogel antibacterial agent was obvious. The field emission characteristics of the dead cells were observed using a field emission electric scanning microscope, which allowed us to observe the specific morphology of the bacteria after death. The solid death of the bacteria was observed by fluorescence staining using a confocal electron microscope.
Key Words: Antibacterial;Nanogel;Dendrimer macromolecule;Neomycin sulfate
目录
摘 要 I
Abstract II
第一章 绪论 5
1.1 抗生素抗菌 5
1.1.1 抗生素发展现状及其种类 5
1.1.2 氨基糖苷类抗生素(AGs)抗菌 5
1.1.3硫酸新霉素研究现状及作用机制 6
1.2 纳米凝胶 7
1.3 肽类树状大分子 7
1.3.1 肽类树状大分子简介 7
1.3. 2 肽类树枝状分子的特点 7
1.4 肽类树状大分子作为药物传输系统 8
1.4.1 肽类树状大分子与药物作用机制 8
1.4.2 在药物传输系统中的前景 8
1.5 本课题的研究背景、意义及内容 9
1.5.1 选题背景与研究意义 9
第二章 树状多肽纳米凝胶的制备与表征 10
2.1实验试剂与仪器 10
2.2树状多肽纳米凝胶的制备 10
2.2.1 G3DSP纳米凝胶的制备 10
2.2.2 G3DSP@NM纳米凝胶制备 11
2.3树状多肽纳米凝胶的表征 11
2.3.1 粒径分析 11
2.3.2 电位分析 12
2.4 本章讨论 13
第三章 纳米凝胶的抗菌性能测试与表征 14
3.1实验试剂与仪器 14
3.2实验材料的制备 14
3.2.1试剂的制备 14
3.2.2细菌的扩大培养 15
3.2.3原菌液浓度的确定 15
3.3实验过程 16
3.3.1纳米凝胶的浓度稀释 16
3.3.2抗菌实验 16
3.4抗菌剂加入前后细菌形貌观察 17
3.5抗菌剂加入前后细菌染色情况 17
3.6实验结果与讨论 18
3.6.1抗菌实验讨论 18
3.7.3 抗菌剂加入前后细菌染色情况分析 19
参考文献 22
致谢 24
第一章 绪论
1.1 抗生素抗菌
1.1.1 抗生素发展现状及其种类
抗生素是生物和化学方面的药物,在各种领域中,尤其是生物药学部分,尤为突出在医学范围内,抗生素是在医药领域是一种伟大的发现[1,2]。至今,抗生素在我国药物治疗方面居于重要地位,其疗效更是尤为显著。然而,抗生素使用过多也有许多负面影响,比如,抗生素使用过多,一些细菌容易产生耐药性,而且会致使抗生素作用下降,导致细菌无法消灭,可能会形成超级细菌这时,我们发现抗生素就不会再起作用,无法达到治疗目的。通过实验发现,合理的使用抗生素,能过较好的提高杀菌效果,为医学发展做出长足的进步。
抗生素的产生因其类型而异。例如,对于青霉素的合成是通过发酵方法而处理完成比如:磺胺,喹诺酮等。根据化学结构可分为:喹诺酮类抗生素,β-内酰胺类抗生素,大环内酯类,氨基糖苷类抗生素等[11,15,20]。
1.1.2 氨基糖苷类抗生素(AGs)抗菌
AGs的抗菌效果较好,是医药方面较为常用的抗菌药物,属于广谱抗生素的一种,对革兰氏阳性菌和革兰氏阴性菌均具有抗菌活性[13,18,19]。自从发现其以来,并因其较好提取,含量丰富已经受到学者的普偏偏认可,并开发了阿米卡星和奈替米星等半合成衍生物。氨基糖苷类抗生素由两个或多个与氨基环醇核心连接的氨基修饰的糖组成。大多数AG含有2-脱氧链霉胺(2-DOS)主要核心,如庆大霉素和妥布霉素,链霉素及其衍生物二氢链霉素不含2-DOS[7,22]。尽管氨基糖苷类抗生素具有耳毒性和肾毒性,但它们仍然是治疗革兰氏阴性菌感染的重要药物,并广泛用于临床应用。抗生素的细菌耐药性可分为三类:内在抗性,适应性抗性和获得性抗性。抗生素的内在抗性,如细菌细胞壁的天然低渗透性,可以限制许多抗生素的摄入;抗生素的适应性抗性是由于环境变化(如营养物浓度的变化)引起的抗生素抗性基因或蛋白质表达水平的变化;通过掺入外来遗传物质,通常是携带多个抗性基因的质粒,或通过现有基因的突变,可以获得抗生素抗性。多重耐药细菌的出现严重影响了抗生素治疗传染病的成功率。了解AGs耐药机制对于耐药性细菌感染性疾病的治疗和新型AG药物的开发具有重要意义。
相关图片展示:

您可能感兴趣的文章
- 在200至300℃的温度下纤维素的水热降解外文翻译资料
- 对O-酰基肟光敏交联剂和丙烯酸丁酯组成的压敏胶一系列光聚合与光降解过程的直接流变学测量外文翻译资料
- 热和紫外线诱导的环氧/环氧丙烯酸酯胶粘剂的制备及其性能外文翻译资料
- 基于光敏可逆固液转换的可调光聚合物胶粘剂外文翻译资料
- 氢氧化物-催化键中近红外吸收的时间演化外文翻译资料
- 利用糖辅助机械力化学剥离技术一步法制备功能化氮化硼纳米片外文翻译资料
- 用于热管理的具有优异力学性能和超高热导率的兼容多功能氮化硼纳米片/聚合物薄膜外文翻译资料
- 油水分离材料用凹土棒复合微球的制备与表征油水分离材料用凹土棒复合微球的制备与表征外文翻译资料
- 单轴拉伸聚乙烯/氮化硼纳米复合薄膜金属状热导率外文翻译资料
- 高导热硅弹性体掺杂石墨烯纳米片和低共熔液体金属合金外文翻译资料


